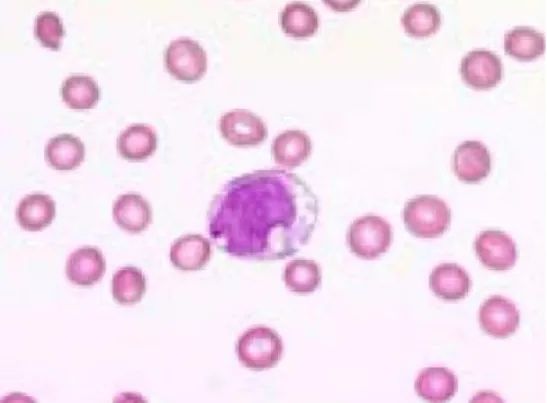
一文了解,什么是骨髓增生异常综合征(MDS) 一文了解,什么是骨髓增生异常综合征(MDS)

最近不少病友在后台留言想要了解骨髓增生异常综合征(MDS)的相关知识。如何发病?如何诊断?症状是什么?均是病友们关心的问题。为了让病友们更深刻的了解疾病,本文将从六方面详解MDS疾病的相关问题。


骨髓增生异常综合征(MDS)是一组起源于造血干细胞,以血细胞发育异常,高风险向急性髓系白血病( AML)转化为特征的难治性血细胞质量异常的高度异质性恶性血液病。任何年龄男、女均可发病,约80%患者大于60岁。MDS可分为原发性MDS和继发性MDS。

MDS发病原因尚未明了,推测是由于生物,化学或物理等因素引起基因突变,染色体异常使某个恶变的细胞克隆性增生。诱变剂如病毒,某些药物(如化疗药),辐射(放疗),工业反应剂(如苯,聚乙烯)以及环境污染等的可致癌作用,诱变剂可引起染色体的重排或基因重排,也可能只引起基因表达的改变导致MDS。
但从细胞培养、细胞遗传学、分子生物学及临床研究均证实,MDS是一种源于造血干/祖细胞水平的克隆性疾病。其发病原因与白血病类似。目前已经证明,至少2种淋巴细胞恶性增生性疾病——成人T细胞白血病及皮肤T细胞型淋巴瘤是由反转录病毒感染所致。亦有实验证明,MDS发病可能与反转录病毒作用或(和)细胞原癌基因突变、抑癌基因缺失或表达异常等因素有关。涉及MDS患者发病的常见原癌基因为N-ras基因。Ras基因家族分为H、N、K三种,MDS患者中最常见的为N-ras基因突变,发生在12、13、61外显子处,突变后N-ras基因编码蛋白表达异常,干扰了细胞正常增生和分化信号,导致细胞增生和分化异常。亦有报告MDS患者p53、Rb抑癌基因表达异常,但上述基因改变多在MDS较晚期RAEB、RAEB-T型患者中发生,在MDS早期RA、RAS中较少,提示用基因突变尚难解释全部MDS患者发病原因。


1、MDS症状
MDS通常起病缓慢,少数起病急骤。贫血患者占90%,常为中等度贫血,表现为面色苍白,头晕乏力,活动后心悸气短等。发热占50%,其中原因不明性发热占10%一15%,感染部位以呼吸道、肛门周围和泌尿系为多。出血占20%,常见于呼吸道、消化道,也有颅内出血者。早期的出症状较轻,多为皮肤粘膜出血,牙龈出血或鼻衄,女性患者可在月经过多。晚期出血趋势加重,脑出血成为患者死亡的主要原因之一。一般从发病开始到转化为白血病,在一年之内约50%以上。
2、MDS体征
一般无特殊体征,仅少数病例有肝、脾、淋巴肿大,脾脏肿大者常为中、轻度。晚期可有胸骨压痛。
3、MDS常见并发症
感染 MDS最常见的并发症主要是感染,最常伴有革兰氏阴性杆菌。血症和细菌性支气管肺炎等,亦可见到霉菌及其它免疫功能紊乱引起感染;有T细胞缺陷者,可引起卡氏肺孢子虫、EB病毒、新型隐球菌的特殊感染。
出血 约20%的MDS患者有出血表现,常见于皮肤、呼吸道、消化道等,也有颅内出血者。
急性白血病 MDS中RA、RAS型演变为急性髓细胞白血病的发生率约为13%,此组病例生存期达50个月;MDS中RAEB与CMML两组中则有35%-40%演变为急性髓细胞白血病,中位生存期仅14-16个月。RAEB-T演变为急性白血病,中位生存期仅为3个月。


MDS诊断需要满足2个必要条件和至少1个主要条件:
1、必要条件:①持续一系或多系血细胞(红细胞、粒细胞、血小板)减少至少4个月(若存在原始细胞增多及MDS相关的细胞遗传学异常,无需4个月);②排除其他可以导致血细胞减少或者发育异常的血液病或者其他疾病。
2、主要条件:①一系或多系骨髓细胞(红系、粒系、巨核系)发育异常≥10%;②环形铁粒幼细胞(铁染色)≥15%或环形铁粒幼细胞≥5%(铁染色)伴SF3B1突变;③骨髓涂片显示骨髓原始细胞占比5%-19%或者外周血涂片原始细胞占比2%-19%(无急性白血病特异性基因存在);④常规核型分析或FISH检查显示典型染色体异常。
3、复合标准:满足(1)但不满足(2)者,但具有典型临床特征时,如大红细胞性输血依赖性贫血,如果符合以下两条或以上考虑临时诊断 MDS,①骨髓病理或/免疫组化支持MDS,如幼稚前体细胞异常定位(ALIP)、CD34+细胞成簇分布和发育异常的小巨核细胞≥10%;②骨髓细胞免疫表型存在多个MDS相关异常,支持单克隆髓系细胞;③分子生物学方法发现髓系细胞存在MDS相关突变,支持克隆造血,此类患者需要定期随访。



要进行MDS的个体化治疗,首先就应该根据患者骨髓原始细胞比例、血常规检查中血红蛋白量、血小板、中性粒细胞数量和染色体核型进行预后评估(见上表)。预后评估系统将MDS患者纳入不同的危险度分层中:极低危、低危、中危、高危和极高危5个大组。每组患者的一般情况、生存时间、治疗方案的选择、治疗反应性存在很大差别,因此,MDS患者的预后分层相当重要。
但是,由于MDS相关检查、诊断和预后分层的复杂性,对于患者们医从性的要求、以及对于就诊医疗机构和接诊医生的要求较高,所以,建议各位病友尽量去血液病专科建设较好、规模较大的医院就诊,以免延误诊断和后续治疗。


1、对症支持治疗:成分输血、预防感染、抗感染、祛铁治疗;
2、促进/改善造血:可考虑用 EPO、雄激素,粒细胞减少感染者可以用粒细胞集落刺激因子或粒细胞-巨噬细胞集落刺激因子(可以理解为升白药);
3、生物反应调节剂:沙利度胺及来那度胺对伴单纯 5q-的MDS有较好的疗效;
4、表观基因组修饰(阿扎胞苷和地西他滨去甲基化):阿扎胞苷和地西他滨能逆转MDS抑癌基因启动子DNA过甲基化,改变基因表达,从基因水平上治疗,延迟MDS向AML转化;
5、联合化疗:适合于年龄低于60岁,高危组尤其是原始细胞增高者;
6、异基因造血干细胞移植:是目前唯一可能治愈MDS的疗法。预后评分系统中相对高危组病人首先应考虑是否适合移植,尤其是年轻、原始细胞增多和伴有预后不良染色体核型者。
7、新药靶向治疗:如促进肿瘤细胞凋亡的BCL2抑制剂维纳托克,可以单药或者联合去甲基化(如阿扎胞苷或者地西他滨)、小剂量阿糖胞苷等;PD1 抗体联合去甲基化治疗;TGF-β抑制剂纠正难治性贫血;抗CD70单克隆抗体;PLK1抗体、FLT3-ITD抑制剂、IDH1/IDH2抑制剂等,已经开展了相关临床试验。



-END-





分享希望 点亮 在看
▼了解更多疾病常识,点击阅读原文~

